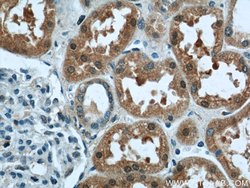
LYN Rabbit anti-Human, Polyclonal, Proteintech 150 &mu;L; Unconjugated:Antibodies,
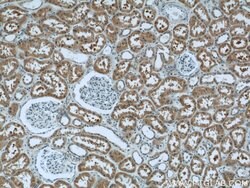
LYN Rabbit anti-Human, Polyclonal, Proteintech 150 &mu;L; Unconjugated:Antibodies,
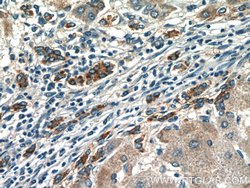
LYN Rabbit anti-Human, Polyclonal, Proteintech 150 &mu;L; Unconjugated:Antibodies,

missing translation for 'onlineSavingsMsg'
Learn More
Learn More
LYN Rabbit anti-Human, Polyclonal, Proteintech
Rabbit Polyclonal Antibody
Brand: Proteintech 18135-1-AP-150UL
This item is not returnable.
View return policy
Description
Prohibitin is an evolutionarily conserved gene that is ubiquitously expressed. It is thought to be a negative regulator of cell proliferation and may be a tumor suppressor. Mutations in PHB have been linked to sporadic breast cancer. Prohibitin is expressed as two transcripts with varying lengths of 3′ untranslated region. The longer transcript is present at higher levels in proliferating tissues and cells, suggesting that this longer 3′ untranslated region may function as a trans-acting regulatory RNA.Specifications
| LYN | |
| Polyclonal | |
| Unconjugated | |
| LYN | |
| JTK8, LYN, Tyrosine protein kinase Lyn | |
| Rabbit | |
| Antigen Affinity Chromatography | |
| RUO | |
| 4067 | |
| -20°C | |
| Liquid |
| Flow Cytometry, Immunocytochemistry, Immunofluorescence, Immunohistochemistry (Paraffin), Immunoprecipitation | |
| 0.39 mg/mL | |
| PBS with 50% glycerol and 0.1% sodium azide; pH 7.3 | |
| P07948 | |
| LYN | |
| LYN Fusion Protein Ag12723 | |
| 150 μL | |
| Primary | |
| Human | |
| Antibody | |
| IgG |
Product Content Correction
Your input is important to us. Please complete this form to provide feedback related to the content on this product.
Product Title
Spot an opportunity for improvement?Share a Content Correction